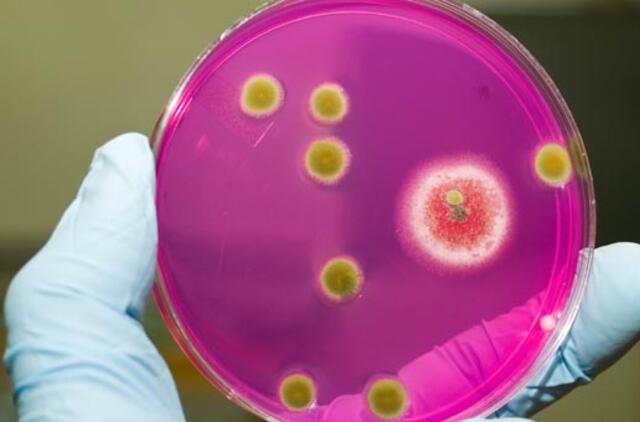
Jei norite išvengti pelėsio, prižiūrėkite namo renovacijos procesą

Sveikatos mokymo ir ligų prevencijos centro Aplinkos sveikatos skyriaus vedėjos pavaduotoja Viktorija Buzytė sako, kad renovuojant namas tarsi įvelkamas į plėvelę.
„Iki tol jis turėjo mikroplyšių – tai tarpai tarp plytų, tarp langų. O čia taip gražiai užvelka naują apvalkalą, įkiša į celofaną ir dingsta natūrali ventiliacija“, – sako specialistė.
Auga net ant stiklo
Pasak Sveikatos mokymo ir ligų prevencijos centro atstovės Viktorijos Buzytės, pelėsis išlenda rudenį, nes tada daugiau drėgmės. Tačiau, jei uoslė įpratusi, žmogus kvapo gali net nepajusti. Žinoma, viskas priklauso nuo to, kiek pelėsis išplitęs. Kartais, įėjus į pastatą ar butą, galima iškart pamatyti juodas sienas.
Pelėsis gali augti ant įvairių medžiagų: medienos, faneros, popieriaus, kartono, sienų apmušalų, tinko, sintetinių medžiagų, odos ir t. t. Idealios sąlygos susidaro tada, kai paviršiuje kondensuojasi drėgmė. Padidėjus drėgmei, pelėsis gali augti ir ant tų medžiagų, kurios nėra jų maisto šaltinis. Pavyzdžiui, ant stiklo. Tuomet pelėsis maitinasi nusėdusiomis dulkėmis. Taip pat pelėsis auga, kai nėra tinkamos ventiliacijos.
Kaip naikinti pelėsį?
Dažniausiai pelėsis ima augti nepakankamai vėdinamose patalpose. V. Buzytė sako, kad vėdinti patalpas paprasta. T. y. iš ryto atidaryti langus 5 min., grįžus namo vėl atidaryti. Jeigu daugiau gaminama, skalbiama, džiovinama, vėdinti reikia dažniau – kas porą valandų. Anot pašnekovės, savaitgaliais žmonės namuose praleidžia daugiau laiko, tai galima 5 min. atidaryti langą vidury dienos, to visiškai pakanka.
Atidaryti langus visiškai pakanka ir nepatariama naudoti ventiliatorių. „Ventiliatoriaus srovė didelė. Mikrosporos atšoka nuo sienų, pasklinda po patalpą ir kažkur nusėda. Atsiradus drėgmei, tinkamoms sąlygoms, toje vietoje pradės augti pelėsis“, – perspėja V. Buzytė.
Pelėsis gali būti šalinamas cheminiu arba mechaniniu būdu. Paklausta, ar tam tiktų dezinfekciniai skysčiai, specialistė sako, kad pirmiausia reikia išsiaiškinti priežastis, kodėl jis atsirado. O jų gali būti daug. „Sienos šalčio tiltas, prastas drenažas, šalia kampo kiauras lietvamzdis. Geriausia ne pačiam tai daryti, o kreiptis į specialistus. Tik pašalinus priežastį, galima pradėti tvarkyti“, – kalba pašnekovė.
Pasak jos, žmonės dažniausiai pamato pelėsį – juodą dėmę, ir puola valyti chloro tirpalu, balikliais ar dar kažkuo. Tai geri būdai, tikina V. Buzytė, nekenksmingi, bet kai pelėsis pats išlenda, jis jau būna pažeidęs pačią medžiagą. „Mes nuvalome paviršinį sluoksnį, bet nenuvalome jo šaknų. Tuomet po kurio laiko pelėsis užauga vėl ir vėl išlenda. Taigi reikia ne tik paviršių valyti, bet ir medžiagą sutvarkyti“, – sako specialistė.
Vienas iš populiariausių būdų, V. Buzytės teigimu, – sieną nugremžti. Tačiau ji sako, kad negalima valyti sauso pelėsio. Reikia suvilgyti chloro tirpalu, balikliu ar dar kažkuo, tada palaukti, kol tirpalas įsigers, pelėsis nuo sienos atšoks, ir tada šveisti. „Šveičiant sausą pelėsį, jis paskleidžiamas ore ir gali nusėsti kitur. Taip pat būtina šveičiant užsimauti gumines pirštines, užsidėti respiratorių, kartais – ir akinius, nes, patekęs į akis, pelėsis gali sukelti uždegimą. Patariama uždaryti duris ir atidaryti langą“, – vardija pašnekovė. Visa tai, pasak jos, reikia daryti vasarą, nes, jeigu sutvarkysime, pelėsį išnaikinsime, o paskui pradėsime taisyklingai vėdinti, jis dings.
Pavojingas sveikatai
Pelėsis kartais tiesiog okupuoja namus. Pelija ir gėlės, ir duona duoninėje. V. Buzytė sako, kad kambarinių augalų dirvožemis ir sunykusios augalų dalys – puikus substratas pelėsiui daugintis. Be to, jei nepagailime vandens, pelėsiui dar palankesnės sąlygos veisiasi. Anot jos, duona pelija visai dėl kitų priežasčių: dažniausiai ji laikoma maišeliuose, susidaro kondensatas, oras nepatenka, ir duona supelija.
Pelijant sienoms, kai kurie žmonės jaučia tam tikrus pojūčius. Sveikatai pavojingi – pelėsių išskiriami toksinai. Tarp didžiulio skaičiaus pelėsinių grybų alergizuojančiomis savybėmis pasižymi apie 300 rūšių. Pelėsiai neigiamai veikia ne tik kvėpavimo takus.
„Pirmi požymiai – galvos skausmas, ašarojančios akys, peršinti nosis, kosulys. Tai visi alergijos požymiai. Ta pati šienligė yra alergija pelėsiui. 1 m3 švaraus oro yra 500 rūšių grybų sporų. Tad mes net nežinome, kas gali sukelti“, – įspėja V. Buzytė.
Kiti požymiai, pasak jos, gali būti dirglumas. Be to, žmonėms, kurie serga kvėpavimo sistemos ligomis, pelėsio poveikis sveikatai kitoks negu sveikiems žmonėms: tai gali būti bronchinė astma, bronchitas, plaučių pneumonija. „O jei žmogus sveikas, organizmas gali ir nereaguoti. Ypač pelėsiai pavojingi mažiems vaikams, senyvo amžiaus žmonėms, nėščioms moterims ir asmenims, sergantiems kvėpavimo sistemos ligomis“, – vardija specialistė.
Pelėsis gali atsirasti ir po renovacijos
Renovuojant pastatas apšildomas, atnaujinamas stogas, pakeičiami langai, tačiau gali būti netinkamai sutvarkyta ventiliacija. Gaivaus oro trūkumas gali sukelti vadinamąjį nesveiko pastato sindromą, t. y. padidėja patalpų oro drėgmė ir užterštumas.
Specialistė sako, kad renovuoti reikia vasarą, kad sienos būtų sausos ir naudojamos tinkamos medžiagos. Ji pastebi, kad dažnai sienos apšiltinamos putplasčiu, nes jis pigesnis už ekovatą. Tačiau, V. Buzytės teigimu, putplastis dažniausiai pjaustomas rankiniu būdu ir atsiranda tarpų. „Taip pat rekomenduojamas 20 cm storis, tačiau žmonės, taupydami pinigus, šildo 10–15 cm. Dar reikia atkreipti dėmesį, kaip medžiagos laikytos iki renovacijos – ar numestos net per lietų, ar apdengtos“, – pataria pašnekovė.
Pasak jos, būtina atkreipti dėmesį ir į ventiliacijos sistemą: jeigu nepadaryta natūrali, galima daryti mechaninę ar kitokia. „Reikia pačiam žmogui dalyvauti renovacijos procese ir jį prižiūrėti“, – pabrėžia V. Buzytė.
Keičiant stogo dangą, taip pat reikia atsižvelgti į oro sąlygas. Pastatas turi būti visiškai sausas. Pašnekovė pasakoja, kad būta atvejų, kai, tvarkant daugiabučio pastato stogą, dvi savaites pylė lietus. Galiausiai darbininkai sulaukė poros dienų, kai nelijo. „Jie nenuplėšė senos dangos, neišdžiovino stogo, o naują dangą uždėjo ant senosios. Drėgmė neturėjo, kur išgaruoti, ir visas namas supelijo, nes iš po senąja danga susidariusių vandens pūslių visas vanduo nutekėjo žemyn“, – įspėja V. Buzytė.

Rašyti komentarą